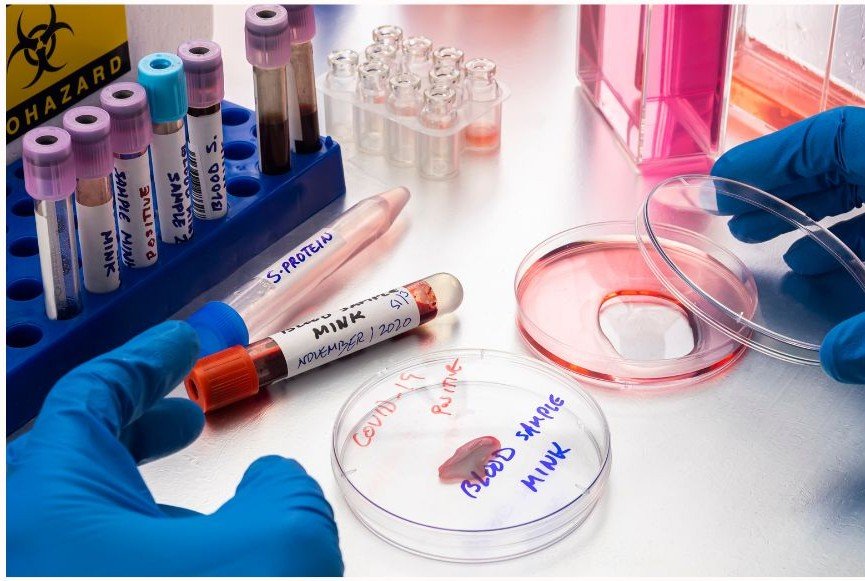
department img

We’re here to care for you and your entire family. Regular visits to the doctor will depend on your age and general health!
- Health assessments
- Home medicine review
- Fractures and dislocations
- Desensitisation injections
the best medical and general practice care!
providing medical care for stickest in our community.
All cardiologists study the disorders of the heart, but the study of adult and child heart disorders are trained to take care...
- Cardiology Department
Some neurologists receive subspecialty training focusing on a particular area of the fields, these training programs called...
- neurocritical care
Pathology is the study of disease, it is the bridge between science and medicine. Also it underpins every aspect of patient care..
- pathology care
Today hospital is recognised as a world renowned institution, not only providing outstanding care and treatment, but improving the outcomes for all.

Call 24HR / 7Days

hear the inspiring stories of our patients
Their doctors include highly qualified practitioners who come from a range of backgrounds & bring with them a diversity of skills and special interests. They also registered nurses available to triage any urgent matters, and the administration and staff all have exceptional skills!!
sami sindhe
Their doctors include highly qualified practitioners who come from a range of backgrounds & bring with them a diversity of skills and special interests. They also registered nurses available to triage any urgent matters, and the administration and staff all have exceptional skills!!
rudra
Their doctors include highly qualified practitioners who come from a range of backgrounds & bring with them a diversity of skills and special interests. They also registered nurses available to triage any urgent matters, and the administration and staff all have exceptional skills!!
Abhishek Yadav
meet our doctors
Our administration and support staff have exceptional skills and trained to assist you with all enquiries.
An M.S. General & Laparoscopy Surgeon with Fellowship in Urology is a highly skilled specialist who performs surgical procedures to treat a wide range of conditions involving the abdomen, digestive system, and urinary tract. Using both traditional open surgery and minimally invasive laparoscopic techniques, this surgeon offers patients faster recovery, less pain, and smaller scars.The fellowship in urology equips them with advanced expertise to manage..
A Gynaecologist is a medical doctor who specializes in the health of the female reproductive system. Their work includes diagnosing and treating conditions related to menstruation, fertility, pregnancy, childbirth, and menopause. Gynaecologists also perform routine check-ups like Pap smears, breast exams and pelvic exams. They may assist in delivering babies, perform surgeries such as hysterectomies or C-sections, and provide guidance on birth control...
Mr. Avinas serves as the Director of Rama Multispeciality Hospital, where he leads the hospital’s mission to provide high-quality, patient-centered healthcare. Under his leadership, the hospital has expanded its services and adopted modern medical technologies to ensure the best outcomes for patients.Dr. Avinas is the Director of Rama Multispeciality Hospital and a dedicated healthcare professional committed to delivering advanced .....
ENT surgeon, also known as an otolaryngologist, specializes in diagnosing and treating medical conditions related to the ear, nose, throat, and nearby areas of the head and neck. Their work includes managing hearing loss, ear infections, balance disorders, sinus issues, nasal blockages, allergies, throat infections, and voice or swallowing difficulties. ENT surgeons also perform surgeries such as removing tonsils, correcting a deviated nasal septum..
Cardiology is the branch of medicine that focuses on the diagnosis, treatment, and prevention of diseases related to the heart and blood vessels. A cardiologist is a doctor who specializes in managing conditions such as heart attacks, high blood pressure, arrhythmias, heart failure, and coronary artery disease. Their work includes conducting physical exams, interpreting tests like ECGs, echocardiograms, and stress tests, and recommending ...
A Gynaecologist is a specialist who focuses on the health and care of the female reproductive organs, including the uterus, ovaries, fallopian tubes, cervix, and vagina. They diagnose and treat issues such as menstrual problems, infertility, hormonal imbalances, infections, and disorders like endometriosis or fibroids. Gynaecologists also perform regular checkups like Pap smears and breast exams to detect early signs of cancer. They provide care during..
Caring For The Health Of You And Your Family.
We Provide All Aspects Of Medical Practice For Your Whole Family!
We pride ourselves on providing the best transport and shipping services available allover the world. Our skilled personnal and processing software, combined with decades of experience! Through integrated supply chain solutions, Equita drives sustainable competitive advantages to some of Australia's largest companies.
- Quality Control System
- Unrivalled workmanship
- 100% Satisfaction Guarantee
01.
fill our medical application
Medisch offers free or low-cost health coverage for adults.
doctors timetable02.
Review Your Family History
Health exams help find problems with early chances which helps.
Start A Check Up03.
Choose Between Our Programs
We have protocols to protect our patients to provide necessary care.
explore programs04.
Introduce To Qualified Doctors
Our administration and support staff all have exceptional people skills
meet our doctors